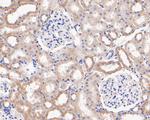
MGST1 Antibody in Immunohistochemistry (Paraffin) (IHC (P))
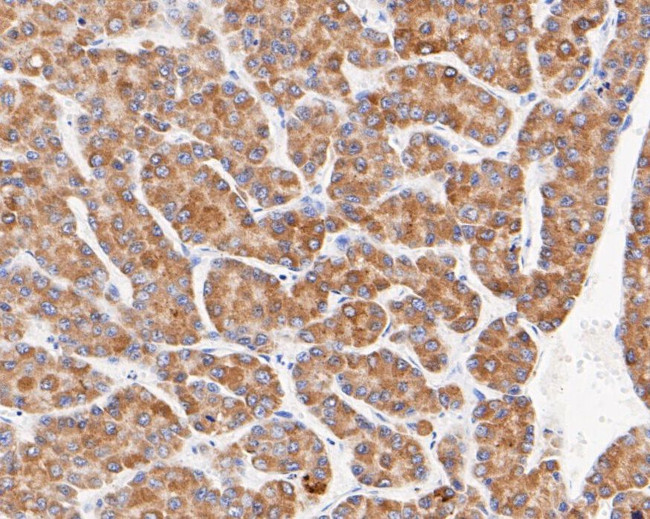
MGST1 Antibody in Immunohistochemistry (Paraffin) (IHC (P))

Search
Invitrogen
MGST1 Monoclonal Antibody (14H2)
{{$productOrderCtrl.translations['antibody.pdp.commerceCard.promotion.promotions']}}
{{$productOrderCtrl.translations['antibody.pdp.commerceCard.promotion.viewpromo']}}
{{$productOrderCtrl.translations['antibody.pdp.commerceCard.promotion.promocode']}}: {{promo.promoCode}} {{promo.promoTitle}} {{promo.promoDescription}}. {{$productOrderCtrl.translations['antibody.pdp.commerceCard.promotion.learnmore']}}
图: 1 / 6
MGST1 Antibody (MA5-34942) in IHC (P)

Please note: We are reviewing Western blot images included in the antibody testing data in our catalog, including those provided by third parties. Unless expressly labeled or annotated as “raw-unedited”, Western blot images included in the antibody testing data in our catalog may have been edited, optimized or otherwise adjusted for presentation.
产品信息
MA5-34942
种属反应
已发表种属
宿主/亚型
分类
类型
克隆号
抗原
偶联物
形式
浓度
规格
纯化类型
保存液
内含物
保存条件
运输条件
RRID
产品详细信息
Positive Control: SiHa cell, HepG2 cell, A549 cell, U937 cell, rat kidney tissue, human liver carcinoma tissue, human colon tissue, human placenta tissue, mouse liver tissue, MCF-7 cell.
靶标信息
The MAPEG (Membrane Associated Proteins in Eicosanoid and Glutathione metabolism) family consists of six human proteins, two of which are involved in the production of leukotrienes and prostaglandin E, important mediators of inflammation. Other family members, demonstrating glutathione S-transferase and peroxidase activities, are involved in cellular defense against toxic, carcinogenic, and pharmacologically active electrophilic compounds. This gene encodes a protein that catalyzes the conjugation of glutathione to electrophiles and the reduction of lipid hydroperoxides. This protein is localized to the endoplasmic reticulum and outer mitochondrial membrane where it is thought to protect these membranes from oxidative stress.
仅用于科研。不用于诊断过程。未经明确授权不得转售。
生物信息学
蛋白别名: MGC14525; Microsomal glutathione S-transferase 1; Microsomal GST-1; Microsomal GST-I
基因别名: GST12; MGST; MGST1
Entrez Gene ID: (Human) 4257